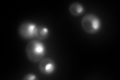
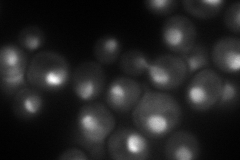
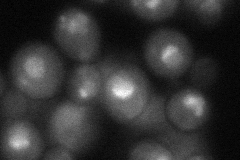
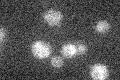

View description
Essential ATP-dependent RNA helicase of the DEAD-box protein family, involved in nonsense-mediated mRNA decay and rRNA processing
Localization:
Intensity:
Fold change:
Significance:
-
C’ GFP library in SD
nucleus:cytosol188.95 -
N' NOP1pr-GFP in SD

nucleus250.858 -
N' TEF2pr-mCherry in SD
nucleus,nucleolus119.936 -
N' NATIVEpr-GFP in SD

nucleus,nucleolus316.429 -
N' TEF2pr-VC and Cyto-VN in SD
nucleus,nucleolus50.9051 -
C’ GFP library in SD+DTT

nucleus.cytosol16.910.08Yes -
C’ GFP library in SD+H2O2

nucleus.cytosol18.110.09Yes -
C’ GFP library in Starvation Media
nucleus,cytosol15.210.08Yes -
C’ GFP library on the background of Pup2-DaMP

nucleus:cytosol -
C’ GFP library on the background of CCT mutant

nucleus:cytosol17.59640.0931235Yes
